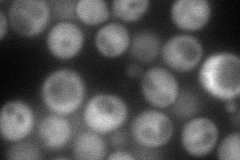
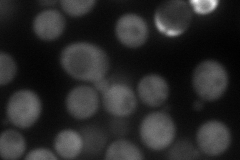

View description
Cytosolic NADP-specific isocitrate dehydrogenase, catalyzes oxidation of isocitrate to alpha-ketoglutarate; levels are elevated during growth on non-fermentable carbon sources and reduced during growth on glucose
Localization:
Intensity:
Fold change:
Significance:
-
C’ GFP library in SD

below threshold15.85 -
N' NOP1pr-GFP in SD
cytosol108.472 -
N' TEF2pr-mCherry in SD
cytosol161.073 -
N' NATIVEpr-GFP in SD

below threshold20.3457 -
N' TEF2pr-VC and Cyto-VN in SD

cytosol63.8881 -
C’ GFP library in SD+DTT

cytosol17.631.11No -
C’ GFP library in SD+H2O2

cytosol18.081.14No -
C’ GFP library in Starvation Media

cytosol18.291.15No -
C’ GFP library on the background of Pup2-DaMP

below threshold -
C’ GFP library on the background of CCT mutant

below threshold17.89811.12902No
